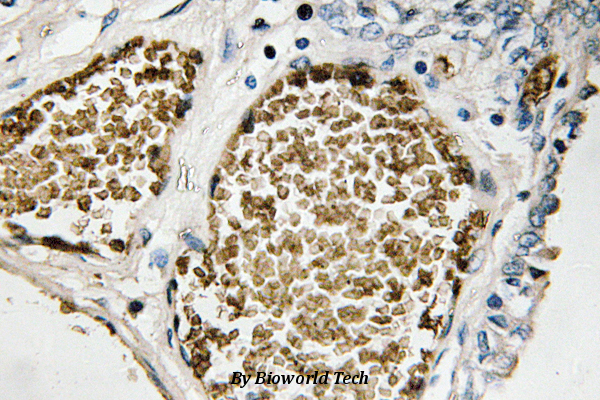

Anti-Fos B (S23) Antibody
A25668
ApplicationsImmunoFluorescence, Western Blot
Product group Antibodies
Overview
- SupplierAntibodies.com
- Product NameAnti-Fos B (S23) Antibody
- Delivery Days Customer7
- ApplicationsImmunoFluorescence, Western Blot
- CertificationResearch Use Only
- ClonalityPolyclonal
- ConjugateUnconjugated
- Estimated Purity>95%
- HostRabbit
- Scientific DescriptionRabbit polyclonal antibody to Fos B (S23)
- UNSPSC12352203

![WB analysis of HeLa cell lysate using GTX11959 Fos B antibody [83B1138].](https://www.genetex.com/upload/website/prouct_img/normal/GTX11959/GTX11959_902_WB_w_23060519_152.webp)


